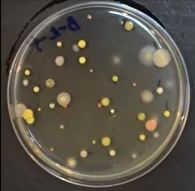

Обработка воздуха
Снижаем уровень микробов и стафилококка в воздухе до 93%
Снижаем уровень микробов и стафилококка в воздухе до 93%
Создаем комфортную среду для посетителей и повышаем маркетинговые показатели
Устраняем неприятные запахи и создаем эффект чистого и свежего воздуха в помещении

Оборудование
Устанавливается прибор под параметры помещения с учетом настроек работы через приложение, с таймером и временем работы.

Дезинфектант
Дезинфектант распространяется в воздухе и устраняет бактерии, вирусы, стафилококк и плесень

ОМЧ составляет
1900 КОЕ/м³
Снижение ОМЧ до 93% сравнительно с исходным уровнем

Снижение ОМЧ до 78% сравнительно с исходным уровнем

Снижение ОМЧ до 52% сравнительно с исходным уровнем
Состав:
Водный раствор гидропероксидных и хлоркислородных соединений: хлорноватистая кислота, гипохлорит-ион, соединения активного кислорода.
Анолит соответствует требованиям Роспотребнадзора по борьбе с COVID-19, одобрен НИИ
Уничтожает вирусы, болезнетворные бактерии. У вирусов иммунитет к анолиту не вырабатывается
Научные исследования подтвердили, что абсолютно безопасен для человека и животных
Запахи — невербальный сигнал, который получает человек и на основе этого принимает решение, здесь хорошо или плохо.
Благодаря коротким нейронным связям обонятельной луковицы с миндалиной запахи приобретают более выраженную эмоциональную окраску, чем зрительные образы.
Тесная связь гиппокампа с обонятельной системой обуславливает способность запахов мгновенно пробуждать воспоминания.
